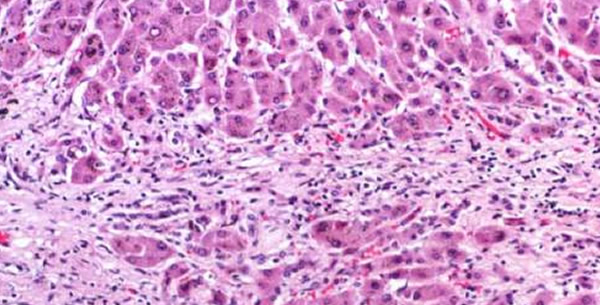

Definicija:
Hronični hepatitis je svaki hepatitis koji traje duže od šest mjeseci.
Etiopatogeneza:
Hronični hepatitis je neriješen u pogledu etiologije, patogeneze, prirode morfoloških lezija i odnosa prema cirozi. Smatra se daje svaki hepatitis koji traje duže od 6 mjeseci hroničan. Javlja se kao:
- hronični perzistenzni i
- hronični aktivni (hronični agresivni hepatitis).
Hronični perzistentni hepatitis
Javlja se u svim dobnim uzrastima. Nekada mu prethodi evidentan akutni hepatitis, ali češće nema podataka o prethodnoj bolesti, ili je hepatitis protekao anikterično.
Klinička prezentacija protiče uglavnom asimptomatski i otkriva se slučajno. Jedini objektivni klinički znak može biti uvećanje jetre.
Laboratorijski nalazi:
Obično se nađe blago povišen bilirubin i blago povišena aktivnost transaminaza. Manji broj bolesnika je HBs-antigen pozitivan.
Terapija:
Terapija nije potrebna, a bolest ima dobru prognozu. Samo izuzetno ovaj oblik pređe u agresivni.
Hronični aktivni hepatitis ili hronični agresivni hepatitis
Raznolike, nejasne etiologije i patogeneze. Najčešći je u dobi 10-30 godina.
Etiopatogeneza:
Vjerovatno nije jedinstvena. Neki bolesnici su HBsAg pozitivni. Prisustvo antitijela na razne tkivne antigene (kod 50% na DNA i antigene glatke muskulature), te povoljan odgovor na imunosupresivnu terapiju govore o ulozi autoimunih mehanizama. Uočena je i familijarna pojava bolesti uz češće prisustvo HLA1 i HLA8 antigena nego u osoba kontrolne grupe, što upućuje na značaj genetskih faktora. Patohistološki se nađu nespecifične upalne promjene i žarišne nekroze sa poremećenom lobularnom građom i razvojem fibroze.
Klinička slika:
Kod manjeg broja bolesnika početak može biti akutan, i sličan akutnom virusnom hepatitisu. Većinom se bolest razvija postepeno i podmuklo sa anoreksijom, malaksalošću, neodređenim tegobama, meteorizmom i abdominalnom boli. Žutica blagog intenziteta je najkonstantniji simptom. Drugi konstantan nalaz je uvećana i tvrda jetra. Splenomegalija i portalna hipertenzija se razvijaju postepeno, te se ezofagogastrični varikoziteti i ascites javljaju u poodmakloj fazi kao ozbiljna komplikacija.
Laboratorijski nalazi:
Aktivnost transaminaza je višestruko povećana, prisutna je umjerena, miješana, pretežno direktna hiperbilirubinemija, sniženi su alburnmi i povećani gama globulini, sniženi su faktori protrombinskog kompleksa, komplement C3 može biti snižen, često se može dokazati prisustvo antitijela na mnoge tkivne antigene.
Liječenje:
Terapija ima za cilj da ublaži ili zaustavi proces, kao i razaranje hepatocita i proliferaciju veziva. Primjenjuju se kortikosteroidi: Prednizon 1-2 mg/kg TT 2-3 sedmice, a nakon kliničkog i biohemijskog poboljšanja doza se progresivno smanjuje u toku 2-4 mjeseca (na 0,5-1 mg/kg TT na drugi dan). U slučaju neuspjeha primjenjuje se Imuran 1-2 mg/kg TT. Liječenje je dugotrajno, mjesecima, ponekad godinama.
Prognoza:
Nekad se proces u jetri može stabilizirati i postati neaktivan, a nažalost većinom prelazi u cirozu.

Be the first to comment